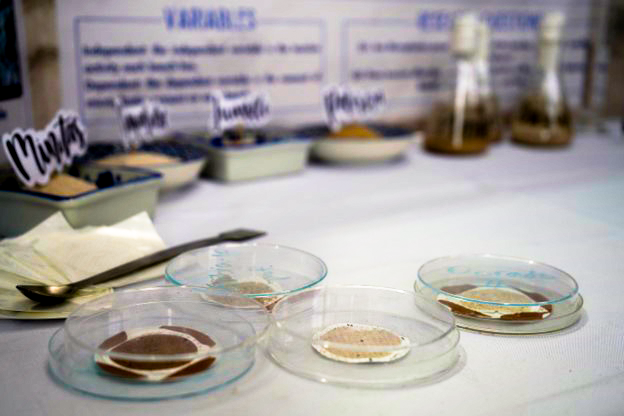

Stars and STEM Stories
GLOBE Dominican Republic: Students’ Research on Microplastics Highlighted at 2024 Events

GLOBE Dominican Republic (GLOBE DR) students presented their
research on microplastics at World Water Day (Giornata Mondiale
Dell'Aqua) in Mantua, Italy, on March 22, 2024. Organizers Sandro
Sutti and Lorella Rigonat were impressed by the outcome of the
Dominican student’s investigations, which
influenced a new law in the Dominican Republic (Law 2025-20)
that will require, among other measures, that importing companies or
manufacturers of plastics use a biodegradability certificate that must
be issued by a laboratory accredited in the corresponding standard.
Other presenters on microplastics at World Water Day included representatives from NASA (using data from the Aqua Satellite), GLOBE Europe and Eurasia, and local Italian schools and universities, such as the University of Reggio Emilia. They presented research on the contamination of several different bodies of water by microplastics.
In October at the XXI GLOBE LAC Regional meeting, the students’ research was also highlighted in the presence of authorities from the Ministries of Education and Environment.
We are not going to stop until we reach every citizen and secure a clean and sustainable environment for the generations to come. —Mrs. Maria de Ruiz-Alma, GLOBE Dominican Republic Country Coordinator